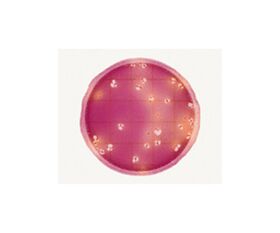

説明
【特徴】
●検査工程を簡単にし、標準化することが可能。
●均一な乾式フィルム状のできあがり培地です。
●培地調整は不要です。
●指示薬によりコロニーが染色され、数えやすいです。
●使用後の廃棄が容易です。
●保管および培養時のスペースを取りません。
●スタンプ法としても使用できます。
●BAMに記載されているベアードパーカー培地+コアグラーゼ試験の方法と同等の方法です。
【仕様】
●付属品:スプレッダー1個
●腸内細菌科菌群数測定用
●入数:1箱(25枚/袋×40袋入)
●★輸送条件:常温
●★旧メーカーJANコード:0707387419110
追加情報
メーカー名:
ネオジェンジャパン
メーカー品番:
6421EB
予定納期:
注文から1~3日で発送